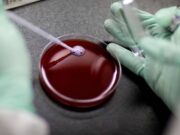
இரத்த சோகை மற்றும் தலசீமியாவுக்கான முதல் மரபணு சிகிச்சையை அங்கீகரித்துள்ள SFDA.

நிதி அமைச்சகத்திற்கான கட்டமைப்பு, ஒழுங்குமுறை வழிகாட்டிக்கு ஒப்புதல் அளித்துள்ள அமைச்சரவை.
இரண்டு புனித மசூதிகளின் பாதுகாவலர் மன்னர் சல்மான் தலைமையிலான அமைச்சரவை, நிதி அமைச்சகத்திற்கான கட்டமைப்பு மற்றும் ஒழுங்குமுறை வழிகாட்டிக்கு ஒப்புதல் அளித்தது.
அமர்வுக்குப் பிறகு சவுதி ஊடகத்துறை அமைச்சர் சல்மான் பின் யூசுப் அல்-தோசாரி,...
பாதுகாப்புத் துறையில் பெண்களின் பங்கைக் கொண்டாடும் வகையில் ‘பாதுகாப்பில் பெண்கள்’ திட்டம் அறிமுகம்.
இரண்டு புனித மசூதிகளின் பாதுகாவலர் மன்னர் சல்மான் தலைமையில், உலக பாதுகாப்பு கண்காட்சி 2024 இன் 2வது பதிப்பு பிப்ரவரி 1, 2024 முதல் நடைபெறும். நிகழ்ச்சியில் அமெரிக்காவுக்கான சவூதி அரேபியாவின் தூதர்...
2023 இல் துணிகர மூலதன முதலீட்டில் சவூதி முதலிடம்.
MENA-ஐ அடிப்படையாகக் கொண்ட துணிகர தரவு தளமான MAGNiTT இன் படி, 2023 ஆம் ஆண்டிற்கான வென்ச்சர் கேபிடல் (VC) நிதியின் அளவு அடிப்படையில் MENA பகுதியில் சவூதி அரேபியா முதல் முறையாக...
இரத்த சோகை மற்றும் தலசீமியாவுக்கான முதல் மரபணு சிகிச்சையை அங்கீகரித்துள்ள SFDA.
இரத்த சோகை மற்றும் தலசீமியா நோயால் பாதிக்கப்பட்ட 12 வயது மற்றும் அதற்கு மேற்பட்ட நோயாளிகளுக்கு முதல் மரபணு சிகிச்சையான காஸ்கேவிக்கு ஒப்புதல் சவூதி உணவு மற்றும் மருந்து ஆணையம் (SFDA) அளித்துள்ளது.
CRISPR/Cas9...
2023 இல் உம்ரா பயணிகளின் எண்ணிக்கை 13.55 மில்லியன்.
ஜித்தா சுப்பர்டோமில் நடைபெற்ற 3வது வருட ஹஜ் மற்றும் உம்ரா சேவைகள் மாநாடு மற்றும் கண்காட்சியில் கலந்து கொண்ட ஹஜ் மற்றும் உம்ரா அமைச்சர் டாக்டர் தவ்ஃபிக் அல்-ரபியா 2023 ஆம் ஆண்டில்...
LPG விநியோகச் சட்டத்தை மீறினால் அபராதம்.
குடியிருப்பு மற்றும் வணிக நோக்கங்களுக்காக உலர் எரிவாயு மற்றும் திரவ பெட்ரோலிய வாயு (LPG) விநியோகச் சட்டம் தொடர்பான செயல்பாடுகளுக்கான மீறல்களின் வரைவு அட்டவணையை எரிசக்தி அமைச்சகம் வெளியிட்டு, சட்ட விதிகளை மீறுபவர்களுக்கு...
வருடாந்திர விருதுகளில் ஊடகத்துறையின் சிறப்பம்சங்களை அமைச்சகம் கொண்டாடுகிறது.
மனித திறன் மேம்பாட்டுத் திட்டத்துடன் இணைந்து ரியாத்தில் நடைபெற்ற பிரமாண்ட விழாவில், ஊடகத்துறை அமைச்சர் சல்மான் அல்-தோசாரி நான்காவது வருடாந்திர மீடியா எக்ஸலன்ஸ் விருது 2023 வென்றவர்களைக் கொண்டாடினார்.
2,355 உள்ளீடுகளில், சுமார் 20...
ஜித்தா சேரிகளை இடிக்கும் பணிகள் குறித்து மதிப்பாய்வு செய்தார் மக்கா துணை அமீர்.
கடந்த ஞாயிற்றுக்கிழமை அமீரகத்தின் தலைமையகத்தில் ஜித்தாவில் உள்ள சேரிகளை அகற்றுவதற்கான செயற்குழு கூட்டத்திற்கு மக்கா பகுதி துணை அமீர் இளவரசர் சவுத் பின் மிஷால் தலைமை தாங்கினார்.
இக்கூட்டத்தில் சம்பந்தப்பட்ட துறைகள் மற்றும் முகமைகளைச்...
காசாவில் அமைதி முயற்சிகளுக்கு உலக மதத் தலைவர்களின் ஆதரவை நாடியுள்ள முஸ்லீம் உலக லீக்.
முஸ்லீம் உலக லீக் (MWL) காசாவில் வன்முறை மற்றும் நடந்து கொண்டிருக்கும் போரை முடிவுக்குக் கொண்டுவருவதை மையமாகக் கொண்ட அவசர மனுவைத் தொடங்கி உலகளாவிய மதத் தலைவர்கள் படைகளில் சேரவும், காசா பகுதியில்...
எரிசக்தி கண்டுபிடிப்புகளை அதிகரிக்க அமைச்சகம் NEOM உடன் இணைந்து செயல்படுகிறது.
அதிநவீன தொழில்நுட்பங்களின் வளர்ச்சியில் கவனம் செலுத்தி, எரிசக்தி துறையில் ஒத்துழைப்பை மேம்படுத்துவதை நோக்கமாகக் கொண்டு, இளவரசர் அப்துல்அஜிஸ் பின் சல்மான் தலைமையிலான சவூதி எரிசக்தி அமைச்சகம் மற்றும் NEOM, CEO Eng. நட்மி...